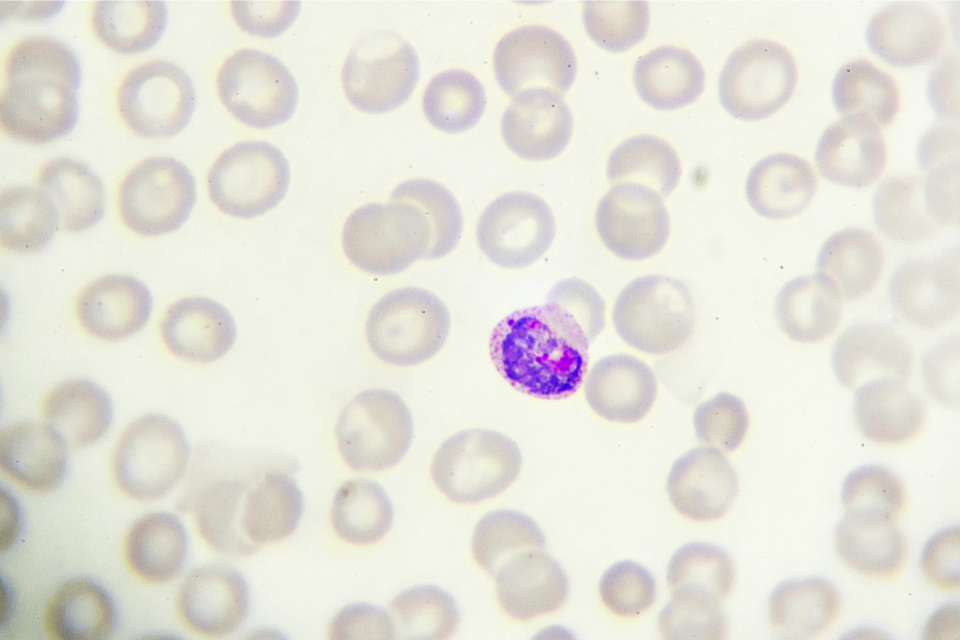
Which are the leading institutions for research into the ‘big three

Clinical Infectious Diseases es una revista médica revisada por pares publicada por Oxford University Press que cubre la investigación sobre patogenia, investigación clínica, médica, microbiología, diagnóstico, inmunidad a los tratamientos y enfermedades causadas por agentes infecciosos. Incluye artículos sobre resistencia a los antimicrobianos, bioterrorismo, infecciones emergentes, seguridad alimentaria, epidemiología y VIH/sida. También publica breves informes, artículos de revisión, editoriales, comentarios y suplementos especiales. La revista se publica en nombre de la Sociedad de Enfermedades Infecciosas de América (Infectious Diseases Society of America)
Según el Journal Citation Reports, la revista tuvo en 2014 un factor de impacto de 8.886, clasificándola en 9.º lugar de 148 revistas en la categoría de "Inmunología",[1] la segunda de entre 78 revistas en la categoría de "Enfermedades Infecciosas"[2] y el puesto noveno de 119 revistas en la categoría de "Microbiología".[3]
Según Academic-accelerator la revista tiene un factor de impacto para el período 2021-2022 de 9.079.[4]
Métricas de revista
- 2022[5]
- Web of Science Group : 9.079
- Índice h de Google Scholar: 353
- Scopus: 9.751
Referencias
Enlaces externos
- Página web oficial